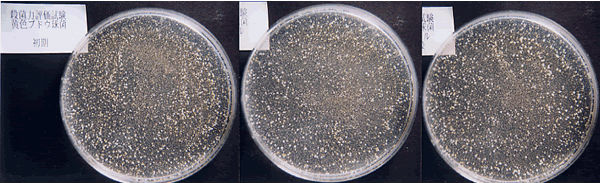

Antimicrobial Test Results
[ Antimicrobial Test Results based on the scientific data ]
A variety of formal test analysis and evaluations have been done on the NeuG7. The antimicrobial evaluation test starting with a "1+ & 3+ hours" of exposure were carried out in October 16, 2002. The Lab testing verified that the NeuG7 created an aerobic environment sufficient to mitigate several types of microbes. In March 2003, the observation period was set up to run on a 24 hour time period. The second antimicrobial test was requested to Kyoto Microbe Laboratory, which is the corporate-juridical-public organization authorized by the Ministry of Health, Labour and Welfare of the Japanese Government. The results, clearly show a 100% of reduction of living organisms. The testing used the same kinds of microbes as the initial testing and reconfirmed those test results. Since the symbols for the test results are shown as "<10", the results were "negative = undetected", which means the perfect antibacterial numbers than expected. The positive tests confirm uses to help mankind.
The antimicrobial results clearly show the ability to reduce and kill microbes, mold and other bacterium make the NeuG7 a very powerful system. These processes stay intact throughout the physical process of water consumption. Affecting Human, animal, plant, fish and earth.
24-hour Observation : Antimicrobial Activity Evaluation Test Results
Laboratory Test Report


Client: Wellness Co.,Ltd.
We conducted the following tests on your samples on March 10, 2003 to verify the following efficacy.
Kyoto Microbe Laboratory (Kyoto Biseibutsu Kenkyusho), the organization authorized by the Ministry of Health, Labour and Welfare of the Japanese Government
16-2, Kubo-cho, Kami-hanayama, Yamashina-ku, Kyoto 607-8464 JAPAN
Test Director: Matsuura
1.Sample name: NeuG7 water (G-7 water)
2.Test Purpose: Antimicrobial activity evaluation
3.Test Method: Carbolic coefficient method 0.1 ml of 107 microbe liquid was inoculated on 10ml of sample. The microbe was cultivated at 25°C while serial measurement was taken on the viable microbe count. As initial microbial dosing, 0.1ml of microbial liquid was inoculated on 10ml of phosphate buffer solution (1/15M, pH 7.2).
4.Sample strain: Escherichia coli IFO-3972
Staphylococcus aureus IFO-12732
Legionella pneumophila KB-1011
Salmonella enteritidis IFO-3313
5.Culture medium: standard agar media (Eiken Chemical Co.,Ltd.)
GVPCa agar media (Nikken biomedical Laboratory)
6.Results
Microbe name Time-dependent change of microbe count
Beginning 24hrs-1 24hrs-2 24hrs-3 Average
E. coil 4.2×105 <10 <10 <10 <10
St. aureus 4.5×105 <10 <10 <10 <10
Leg.pneumophila 4.6×105 <10 <10 <10 <10
Sal. enterritidis 4.7×105 <10 <10 <10 <10
Control
Microbe name Time-dependent change of microbe count
Beginning 24hrs-1 24hrs-2 24hrs-3 Average
E. coil 4.2×105 4.8×105 4.7×105 5.3×105 4.9×105
St. aureus 4.5×105 4.3×105 3.9×105 3.9×105 4.0×105
Leg.pneumophila 4.6×105 4.2×105 4.5×105 4.6×105 4.4×105
Sal. enterritidis 4.7×105 4.7×105 4.9×105 4.4×105 4.7×105
*<10:Negative Unit:CFU/mL
24-hour Observation Escherichia coli
Tap Water

At the beginning
8+ hours
24+ hours
NeuG7 Water

At the beginning
8+ hours
24+ hours
24-hour Observation Staphylococcus Aureus
Tap Water
At the beginning
At the beginning
8+ hours
8+ hours
24+ hours
24+ hours
NeuG7 Water
At the beginning
8+ hours
8+ hours
24+ hours

24-hour Observation Salmonella Enteritidis
Tap Water
At the beginning
8+ hours
24+ hours

NeuG7 Water
At the beginning
8+ hours
24+ hours

As observed by client users…The pig farmers and the chicken farmers using the NeuG7 products, report that Salmonella, Escherichia coli and other bacteria had decreased. These observations initiated the formal testing to gain data on the antimicrobial opportunities. Testing was requested to be conducted by the authorized public institution the day after the farm information was received. As a result, it was confirmed. The quantifiable results show that the NeuG7 system can add many valuable benefits to operations where microbes are an issue and needing controls.
| English home | Wha's NeuG7? | Antimicrobial Test Results | The International Patent | Contact us |
Japanese site | Chinese site
2017 Copyrights C Wellness co,.ltd.